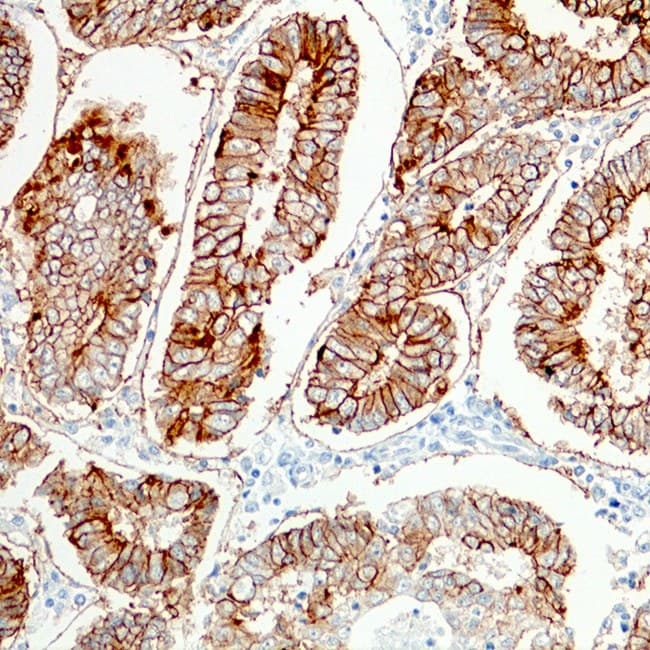

Anti-EpCAM CE/IVD para IHC - Citopatología
La Molécula de Adhesión Celular Epitelial (EpCAM) es una glicoproteína transmembrana de tipo I altamente conservada que media la adhesión célula-célula en los epitelios. La EpCAM se expresa en la mayoría de las células epiteliales normales y malignas. Ep-CAM también se conoce como molécula de adhesión celular epitelial o MOC31 o Ber-EP4. Normalmente está presente en la mayoría de las superficies basolaterales de las células epiteliales normales y está ausente en las células mioepiteliales, los hepatocitos, los epitelios escamosos adultos, las células mesoteliales y los fibroblastos. El anti-EpCAM tiñe la mayoría de los adenocarcinomas y tumores neuroendocrinos, incluidos los carcinomas de células pequeñas. Una minoría de carcinomas renales de células claras, oncocitomas renales y carcinomas hepatocelulares se tiñen positivamente para EpCAM, mientras que el Anti-EpCAM tiñe casi todos los carcinomas de células basales. Los anti-EpCAM tiñen con mayor frecuencia el carcinoma de células renales cromófobo, el carcinoma papilar de células renales y el colangiocarcinoma. El anti-EpCAM puede ser útil para distinguir la malignidad en las cavidades peritoneal y pleural.
Resultados de su búsqueda : 3 Producto encontrado
Refine su búsqueda :
- Unconjugated 3
- human 3
- mouse 3
- Primary antibody
- IHC 3
- IHC567 3
